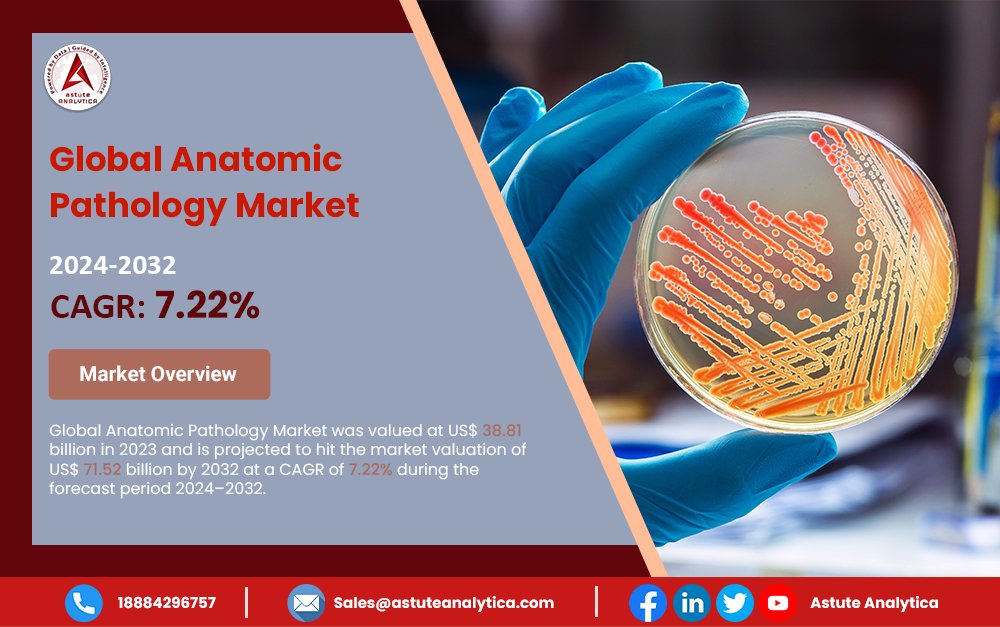
AstuteAnalytic1's tweet image. 𝐆𝐥𝐨𝐛𝐚𝐥 𝐀𝐧𝐚𝐭𝐨𝐦𝐢𝐜 𝐏𝐚𝐭𝐡𝐨𝐥𝐨𝐠𝐲 𝐌𝐚𝐫𝐤𝐞𝐭 𝐨𝐧 𝐚 𝐆𝐫𝐨𝐰𝐭𝐡 𝐓𝐫𝐚𝐣𝐞𝐜𝐭𝐨𝐫𝐲!

The Global #Anatomic #pathology  #Market was valued at US$ 38.81 billion in 2023 and is projected to reach US$ 71.52 billion by 2032, growing at a CAGR of 7.22% (2024–2032).

#anatomic результаты поиска
Open Rank Faculty-Anatomic or Clinical Pathology and Pathology Education University of Illinois Chicago See the full job description on jobRxiv: jobrxiv.org/job/university… #anatomic #clinical #ClinicalMedicine #pathology #ScienceJobs jobrxiv.org/job/university…
Special thanks to Andy Matlock, MS and @EmorySurgery for the 120+ #anatomic illustrations, with more underway. SCORE is adding more visuals to educational content, specifically high-yield images and learning diagrams. @EmoryUniversity @APDSurgery #MedEd #SurgEd #ABSITE #GenSurg

@Ricoh, @Stratasys, & @Axial3D Partner to Increase Access to #3DPrinted #Anatomic #MedicalModels bit.ly/3FLCZvm #3dhealslattice #medical3dprinting

# PATHOLOGIST # SONOLOGIST # RADIOLOGIST # ONCOLOGIST # DERMATOLOGIST #Medical pathologist #Anatomic pathologist# #Ultrasound specialist# Ultrasonics specialist# Medical imaging specialist #Radiodiagnostic specialist#Cancer treatment specialist#Tumor doctor # Dermatologist

According to Precision Business Insights #Anatomic #Pathology Market size was valued at USD 37.9 billion in 2021 and is expected to reach a value of USD 58.9 billion by 2028 witnessing a CAGR rate of 6.5% during the forecast period 2022-2028. precisionbusinessinsights.com/market-reports…
#Prenatal and Early Postnatal Outcomes for #Fetuses with #Anatomic or Functional Renal Agenesis 🔗 karger.com/Article/FullTe… ✍ Ogundipe E. A. et al. 📖 #FetalDiagnTher #Amnioinfusion #BilateralRenalAgenesis

𝐱𝐥_𝐬𝐫𝐬 • 𝐌𝐨𝐝𝐮𝐥𝐚𝐫 𝐓𝐨𝐭𝐚𝐥 𝐒𝐡𝐨𝐮𝐥𝐝𝐞𝐫 . XL-SRS recreates the #anatomic reality of the #body in joint fixation #technology , which improves mobility and greatly enhances the #quality of life. #shoulder #shoulderreplacement #doctor #surgeon #surgery #hospitals

Explore dedicated lab software solutions for anatomical testing in laboratory medicine that offer unparalleled features to improve lab efficiency and performance. #anatomy #anatomic #pathology


Guzylak, Vanessa; Anatomic-Radiologic Correlation with... #Anatomy #Anatomic rave.ohiolink.edu/etdc/view?acc_…
On this podcast I discuss same day outpatient total shoulder arthroplasty #shoulder #anatomic #TSA #stemless #shoulderreplacement #shoulderrehab #orthopedic #ortho #orthopedicsurgery #valencia #santaclarita #scv #SCOI #socal henrymayo.com/news-publicati… @SCOIOrthoNews @HenryMayoHosp

Mr. Roger’s neighborhood is hear. You have 2 for a reason. The trees are blooming #Renaissance #Phase580 #anatomic✅
"I spent half my life in the military, and I used to come home, take off my little soldier hat, put on my painter's hat, and there I'd build the kind of world that I wanted. It was peaceful, it was quiet, there was no hassles, nobody was yelling. And it was good, everything was

Learn how advanced anatomic pathology software optimizes laboratory workflow management for pathology practices by supporting workflow automation and digital pathology. bit.ly/3K4TgNY #anatomic #pathology #laboratory #management #testing #reporting #software #LIS

I have a pair of barefoot shoes that needs a new owner (for those that care about their feet 👣) Great quality, got a wrong size.. #anatomic Size 42 (Fits 41), Material Cotton / Canvas



#Extracting #Forceps, #Anatomic #Handle, #Size13, #Diamond. 𝐄𝐦𝐚𝐢𝐥: [email protected] #scissors #orthopedic #opthalmic #intestinal #cardic #gynecology #ear #ent #beautycare #instruments #holloware #viral #medmaxindustry

Dr. Ferhina Ali will be sharing data on #clinical and #anatomic outcomes and #treatment patterns for #patients in the real world as well as practice management strategies for patients with #retina vascular disease. View the agenda at bit.ly/368Yk2N #ophthalmology
#bodylanguage #Anatomic mdpi.com/2218-6581/9/4/… #NonAnatomical dictionary.cambridge.org/dictionary/eng…
PERSISTENCE OF THE LEFT SUPERIOR #VENACAVA AS AN #ANATOMIC ALVARIANT by #TacuriJ in #JournalofClinicalCaseReportsMedicalImagesandHealthSciences jmedcasereportsimages.org/jcrmhs-v2-1064/
jmedcasereportsimages.org
JCRMHS-V2-1064
Visit the post for more.
The Global #Anatomic #Pathology #Market, valued at $38.81B in 2023, is forecasted to reach $71.52B by 2032, growing at a CAGR of 7.22% (2024–2032). Request this Sample Report Here:- astuteanalytica.com/request-sample… #HealthcareMarket #AnatomicPathology #MarketInsights #PathologyTrends

Open Rank Faculty-Anatomic or Clinical Pathology and Pathology Education University of Illinois Chicago See the full job description on jobRxiv: jobrxiv.org/job/university… #anatomic #clinical #ClinicalMedicine #pathology #ScienceJobs jobrxiv.org/job/university…
🧠🩺 Need accurate medical or anatomical illustrations that look truly professional?shorturl.at/P4mTL I design high-quality, realistic medical & surgical illustrations for textbooks, research, and presentations. #MedicalIllustration #Anatomic

Creating an Anatomical System Using ZBrush & Blender and the use of Bezier curves 80.lv/articles/build… #blender #anatomic #3dmodel #zbrush #art #medicalillustration

I look forward to present at the companion meeting of @CAPA_comm #CAP25. I will discuss the opportunities & resources of #AI in #Anatomic #Pathology. Happy to know that we are moved to a bigger room due to high number of registrations to our session👏@Pathologists @MoffittNews
The CAPA–CAP Companion Session at #CAP25 lands Sat 9/13, 2-4 PM ET. Catch cutting-edge perspectives in diagnostic pathology from Drs Marilyn Bui, Kiril Trpkov, Qihui (Jim) Zhai & Elizabeth Montgomery! Moderators: Drs Larry Wang & Xiaoying Liu. More CAPA info below. #PathTwitter


@MopecCo Group & @LumeaDigital Partner to Drive Pathology Innovation itdigest.com/healthtech/sma… #anatomic #digitalpathology #forensicpathologyequipment #ITDigest #Lumea #MopecGroup #news #SmartMedicalDecvices
PERSISTENCE OF THE LEFT SUPERIOR #VENACAVA AS AN #ANATOMIC ALVARIANT by #TacuriJ in #JournalofClinicalCaseReportsMedicalImagesandHealthSciences jmedcasereportsimages.org/jcrmhs-v2-1064/
jmedcasereportsimages.org
JCRMHS-V2-1064
Visit the post for more.
Anatomic CircusがTVに取材されました。3月20日の18時15分から関西読売テレビten.にて。是非ご覧下さい♪

🦾A new biomimetic robotic finger integrates cartilages, ligaments, and pulleys to mimic human anatomy. It is driven by six SMA actuators and achieves lifelike motion.- by @Askar51538387, et al. 🔎Read more at: mdpi.com/2313-7673/9/3/… #biomimetic #robotics #anatomic #system

𝐆𝐥𝐨𝐛𝐚𝐥 𝐀𝐧𝐚𝐭𝐨𝐦𝐢𝐜 𝐏𝐚𝐭𝐡𝐨𝐥𝐨𝐠𝐲 𝐌𝐚𝐫𝐤𝐞𝐭 𝐨𝐧 𝐚 𝐆𝐫𝐨𝐰𝐭𝐡 𝐓𝐫𝐚𝐣𝐞𝐜𝐭𝐨𝐫𝐲! The Global #Anatomic #pathology #Market was valued at US$ 38.81 billion in 2023 and is projected to reach US$ 71.52 billion by 2032, growing at a CAGR of 7.22% (2024–2032).
@Ricoh, @Stratasys, & @Axial3D Partner to Increase Access to #3DPrinted #Anatomic #MedicalModels bit.ly/3FLCZvm #3dhealslattice #medical3dprinting

I have a pair of barefoot shoes that needs a new owner (for those that care about their feet 👣) Great quality, got a wrong size.. #anatomic Size 42 (Fits 41), Material Cotton / Canvas



Special thanks to Andy Matlock, MS and @EmorySurgery for the 120+ #anatomic illustrations, with more underway. SCORE is adding more visuals to educational content, specifically high-yield images and learning diagrams. @EmoryUniversity @APDSurgery #MedEd #SurgEd #ABSITE #GenSurg

Explore dedicated lab software solutions for anatomical testing in laboratory medicine that offer unparalleled features to improve lab efficiency and performance. #anatomy #anatomic #pathology


# PATHOLOGIST # SONOLOGIST # RADIOLOGIST # ONCOLOGIST # DERMATOLOGIST #Medical pathologist #Anatomic pathologist# #Ultrasound specialist# Ultrasonics specialist# Medical imaging specialist #Radiodiagnostic specialist#Cancer treatment specialist#Tumor doctor # Dermatologist

🦾A new biomimetic robotic finger integrates cartilages, ligaments, and pulleys to mimic human anatomy. It is driven by six SMA actuators and achieves lifelike motion.- by @Askar51538387, et al. 🔎Read more at: mdpi.com/2313-7673/9/3/… #biomimetic #robotics #anatomic #system

#Prenatal and Early Postnatal Outcomes for #Fetuses with #Anatomic or Functional Renal Agenesis 🔗 karger.com/Article/FullTe… ✍ Ogundipe E. A. et al. 📖 #FetalDiagnTher #Amnioinfusion #BilateralRenalAgenesis

🧠🩺 Need accurate medical or anatomical illustrations that look truly professional?shorturl.at/P4mTL I design high-quality, realistic medical & surgical illustrations for textbooks, research, and presentations. #MedicalIllustration #Anatomic

𝐱𝐥_𝐬𝐫𝐬 • 𝐌𝐨𝐝𝐮𝐥𝐚𝐫 𝐓𝐨𝐭𝐚𝐥 𝐒𝐡𝐨𝐮𝐥𝐝𝐞𝐫 . XL-SRS recreates the #anatomic reality of the #body in joint fixation #technology , which improves mobility and greatly enhances the #quality of life. #shoulder #shoulderreplacement #doctor #surgeon #surgery #hospitals

#Extracting #Forceps, #Anatomic #Handle, #Size13, #Diamond. 𝐄𝐦𝐚𝐢𝐥: [email protected] #scissors #orthopedic #opthalmic #intestinal #cardic #gynecology #ear #ent #beautycare #instruments #holloware #viral #medmaxindustry

Περιορισμένη διαθεσιμότητα‼️Προλάβετε🤩💥⚡️🍾🎉🎊 anatomic-footwear.com #anatomic #anatomicfootwear #saveyourfeet #save_your_feet #pharmacy #φαρμακειο #supersoft #shoes #ανατομικά #woman #easywalking #anatomicsandals #casual #safestep #safe_step

Creating an Anatomical System Using ZBrush & Blender and the use of Bezier curves 80.lv/articles/build… #blender #anatomic #3dmodel #zbrush #art #medicalillustration

On this podcast I discuss same day outpatient total shoulder arthroplasty #shoulder #anatomic #TSA #stemless #shoulderreplacement #shoulderrehab #orthopedic #ortho #orthopedicsurgery #valencia #santaclarita #scv #SCOI #socal henrymayo.com/news-publicati… @SCOIOrthoNews @HenryMayoHosp

#Extracting #Forceps #Anatomic #Handle #28 𝐄𝐦𝐚𝐢𝐥: [email protected] #scissors #orthopedic #opthalmic #intestinal #cardic #gynecology #ear #ent #beautycare #instruments #holloware #viral #medmaxindustry #surgical #dental #beautyproducts

Kazališna predstava "Scene iz bračnog života", u kojoj igraju Zlatan Vidović i Tamara Krcunović, u režiji Ane Tomić, premijerno će se izvesti u četvrtak, 16. veljače 2023. godine u HKD-u na Sušaku u Rijeci. Dan poslije, u petak, 17. #AnaTomić zgportal.com/zgdogadanja/pr…

Learn how advanced anatomic pathology software optimizes laboratory workflow management for pathology practices by supporting workflow automation and digital pathology. bit.ly/3K4TgNY #anatomic #pathology #laboratory #management #testing #reporting #software #LIS

UTCVM hosted 37 #anatomic #pathology trainees from 14 veterinary schools in the US, Canada & 5 governmental or private laboratories in the US and Korea for the 2023 Current Literature and Image Interpretation course, an intensive 5-day course. @DavisThompsonF1 was the sponsor.

Something went wrong.
Something went wrong.
United States Trends
- 1. Venezuela N/A
- 2. Aaron Judge N/A
- 3. Bryce Harper N/A
- 4. #WorldBaseballClassic N/A
- 5. Team USA N/A
- 6. Mark DeRosa N/A
- 7. Whitlock N/A
- 8. NC State N/A
- 9. Skubal N/A
- 10. World Series N/A
- 11. Eugenio Suarez N/A
- 12. Mason Miller N/A
- 13. #MarcusIsLucky N/A
- 14. Yankees N/A
- 15. Palencia N/A
- 16. Charles Barkley N/A
- 17. Will Wade N/A
- 18. Vitale N/A
- 19. Schwarber N/A
- 20. Padres N/A










































































